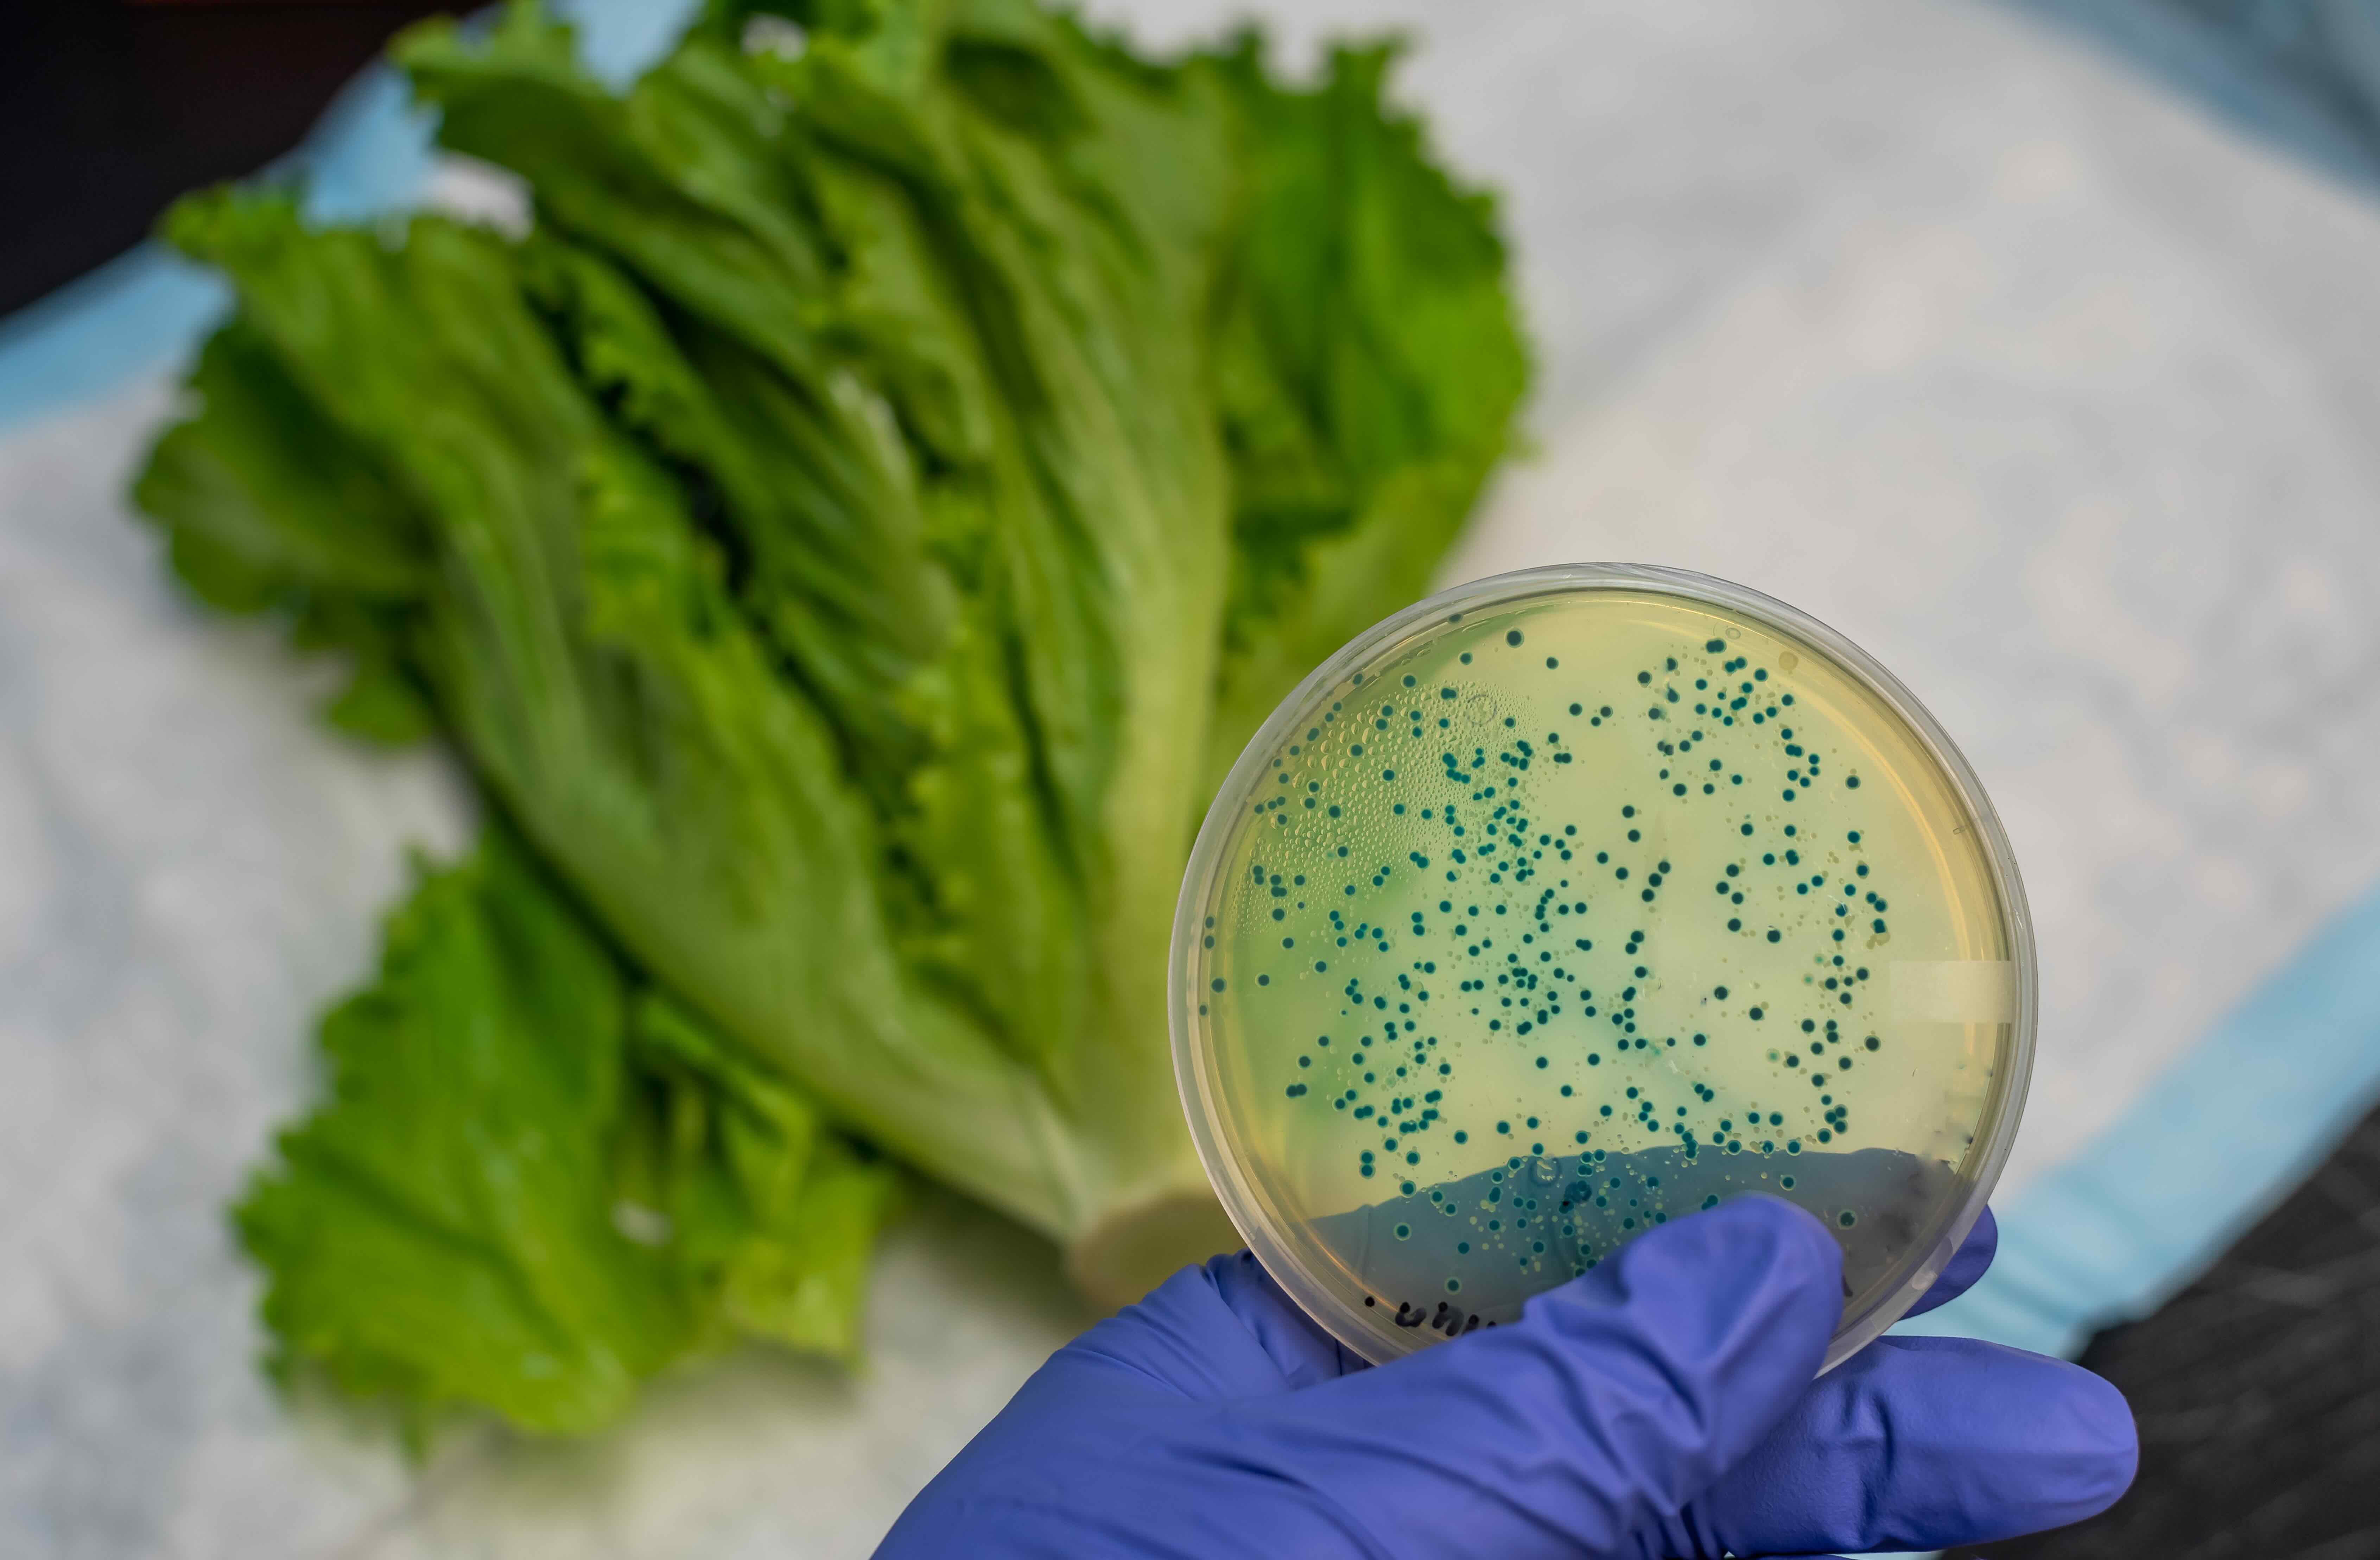
person holding petri dish

Kennesaw State University is dedicated to creating knowledge that improves the lives of all Georgians.
At KSU, we are leading the charge in the fight against opioid abuse, ensuring veterans receive the care they need, and building a world where people with diabetes can check their blood sugar without drawing blood.
Our innovations do not just stay in the lab or sit on a shelf. We work to maximize our impact by partnering with local and regional stakeholders, ensuring we reach those in need.
Around the world, ordinary people face extraordinary challenges. These challenges drive our research. Our research turns questions into progress.

Improving Health, Saving Lives

Enhancing Human Capability

Understanding Our World

Innovation Through Creativity

As Georgia navigates a widespread opioid addiction crisis, Kennesaw State University researchers are training budding nurses in addressing substance-use disorders.
“With these funds dedicated to our four priorities, we have a unique opportunity to make a meaningful impact on the lives of Georgians affected by the opioid crisis."
learn how KSU is fighting the opioid crisisThe partnership between the Center for the Advancement of Military and Emergency Services (AMES) Research and Georgia Department of Veterans Services has led to the completion of more than 7,000 suicide assessments across 134 counties in Georgia.
“Our collaborative, community-focused work is crucial to ensure Georgia’s veterans get the right help — where they are — when they need it."
learn how KSU is serving those who serve

GlucoCheck is a ring-like sensor that uses light absorption technology to estimate glucose levels without using blood samples, providing a user-friendly alternative to finger pricks.
“We are excited about how this device will help people with diabetes, which affects about one in every 10 people in the United States."
learn how KSU is easing the burden on people with diabetesThe team’s mission is to create a low-cost, AI-driven solution that deters destructive wildlife from farmland without the need for traditional fencing or human patrols.
“We’re giving (farmers) a tool that lets them rest at night while knowing their fields are protected. The feedback we’ve received from farmers so far has been overwhelmingly positive."
learn how KSU is helping Georgia's farmers

The project, which is a collaboration between the City of Chattahoochee Hills and the West Atlanta Watershed Alliance, combines real-time monitoring with AI-driven forecasting to predict spikes in bacteria contamination before they occur.
“The bacterial forecasting system helps everyday people by ensuring cleaner and safer water. By improving water quality and reducing contamination risks, it protects public health and enhances recreational experiences."
learn how KSU is bringing real-time monitoring to GeorgiansThe device is designed to detect pathogens such as salmonella and E. coli, eliminating the guesswork in identifying contaminated food.
“Food safety is a really important issue for the public, and I realized that millions of people are affected by foodborne illness each year."
learn how KSU is advancing food safety
The award-winning Interactive Research Methods Lab (IRML) helps students learn how to start with a research topic and map out the steps of a research project.
“The less resources your school district has, the more useful Hopscotch for AP Research and the Air-Lab is going to be for you."
learn how KSU is providing Georgia high schoolers with research toolsResearchers at Kennesaw State and Georgia Tech partnered to teach movement to artificial intelligence through improvisational dance, culminating with a first-of-its-kind performance: artificial intelligence — in the form of an avatar projected onto a screen — improvise=ing movement with human dance partners.
“The combination of both dance and science provides limitless discoveries, and with the advanced technology that we have today this combination can be explored in depth.”
learn how KSU is blending dance with innovative technology